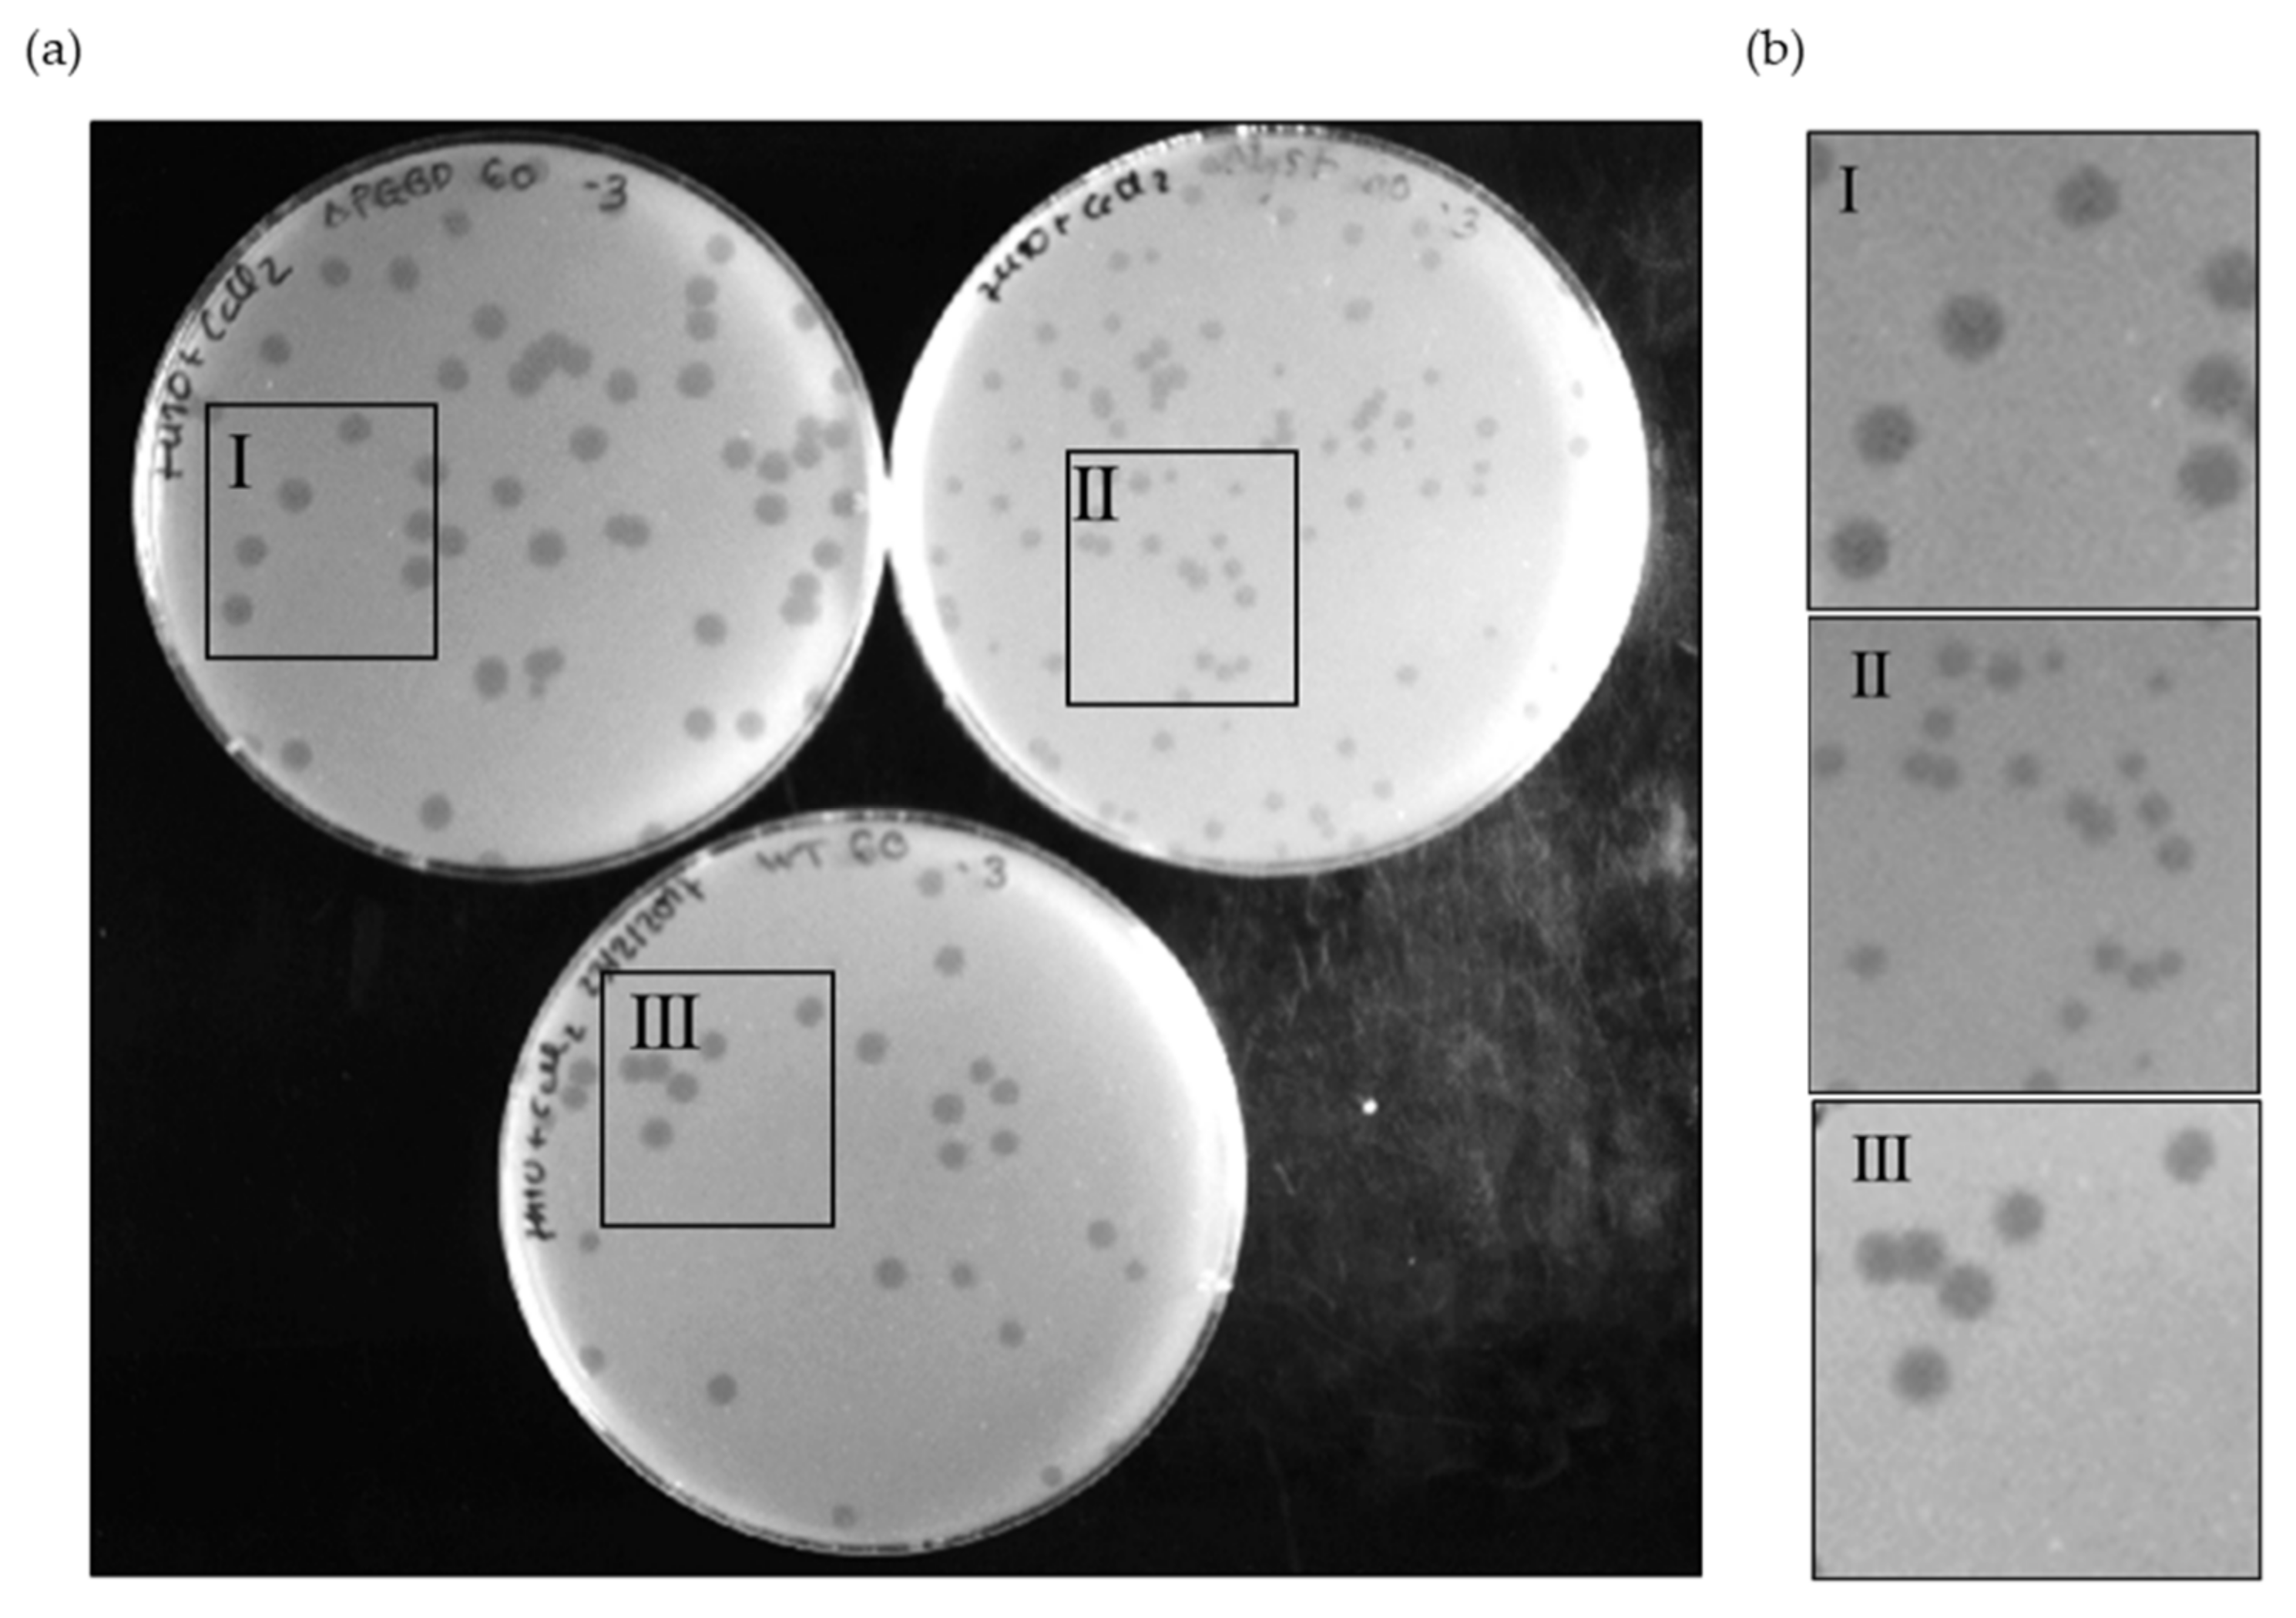
Viruses 13 01377 g004 550

The Mycobacteriophage Ms6 LysB N-Terminus Displays Peptidoglycan Binding Affinity
Abstract
:1. Introduction
2. Materials and Methods
2.1. Bacterial Strains, Plasmids, Bacteriophages and Culture Conditions
2.2. DNA Manipulation and Plasmid Construction
2.3. Protein Expression and Purification
2.4. Cells Binding and Fluorescence Assay
2.5. Preparation and Purification of Peptidoglycan (PG)
2.6. Peptidoglycan Binding Assays
2.7. Construction of Ms6lysB∆PGBD
2.8. One-Step Growth Experiments
3. Results
3.1. Sequence Analysis of Ms6 LysB Reveals a Putative PGBD

3.2. The Ms6 LysB N-Terminus Binds to Mycobacterial Cells
3.3. Ms6 LysB N-Terminus Binds to Peptidoglycan
3.4. Deletion of PGBD from LysB Results in a Faster Rise Period
4. Discussion
Supplementary Materials
Author Contributions
Funding
Institutional Review Board Statement
Informed Consent Statement
Acknowledgments
Conflicts of Interest
References
- Young, R.; Wang, I.N. Phage lysis. In The Bacteriophages; Calendar, R., Ed.; Oxford University Press: New York, NY, USA, 2006; pp. 104–126. [Google Scholar]
- Young, R. Phage lysis: Three steps, three choices, one outcome. J. Microbiol. 2014, 52, 243–258. [Google Scholar] [CrossRef]
- Berry, J.; Rajaure, M.; Pang, T.; Young, R. The spanin complex is essential for lambda lysis. J. Bacteriol. 2012, 194, 5667–5674. [Google Scholar] [CrossRef] [Green Version]
- Cahill, J.; Young, R. Phage lysis: Multiple genes for multiple barriers. Adv. Virus Res. 2019, 103, 33–70. [Google Scholar] [CrossRef]
- Summer, E.J.; Berry, J.; Tran, T.A.T.; Niu, L.; Struck, D.K.; Young, R. Rz/Rz1 lysis gene equivalents in phages of gram-negative Hosts. J. Mol. Biol. 2007, 373, 1098–1112. [Google Scholar] [CrossRef]
- Berry, J.; Summer, E.J.; Struck, D.K.; Young, R. The final step in the phage infection cycle: The Rz and Rz1 lysis proteins link the inner and outer membranes. Mol. Microbiol. 2008, 70, 341–351. [Google Scholar] [CrossRef] [Green Version]
- Rajaure, M.; Berry, J.; Kongari, R.; Cahill, J.; Young, R. Membrane fusion during phage lysis. Proc. Natl. Acad. Sci. USA 2015, 112, 5497–5502. [Google Scholar] [CrossRef] [Green Version]
- Kȩdzierska, S.; Wawrzynów, A.; Taylor, A. The Rz1 gene product of bacteriophage lambda is a lipoprotein localized in the outer membrane of Escherichia coli. Gene 1996, 168, 1–8. [Google Scholar] [CrossRef]
- Berry, J.; Savva, C.; Holzenburg, A.; Young, R. The lambda spanin components Rz and Rz1 undergo tertiary and quaternary rearrangements upon complex formation. Protein Sci. 2010, 19, 1967–1977. [Google Scholar] [CrossRef] [PubMed] [Green Version]
- Young, R. Phage lysis: Do we have the hole story yet? Curr. Opin. Microbiol. 2013, 16, 790–797. [Google Scholar] [CrossRef] [Green Version]
- Pimentel, M. Genetics of phage lysis. Microbiol. Spectr. 2014, 2, MGM2-0017-2013. [Google Scholar] [CrossRef] [PubMed] [Green Version]
- Catalão, M.J.; Pimentel, M. Mycobacteriophage lysis enzymes: Targeting the mycobacterial cell envelope. Viruses 2018, 10, 428. [Google Scholar] [CrossRef] [Green Version]
- Hoffmann, C.; Leis, A.; Niederweis, M.; Plitzko, J.M.; Engelhardt, H. Disclosure of the mycobacterial outer membrane: Cryo-electron tomography and vitreous sections reveal the lipid bilayer structure. Proc. Natl. Acad. Sci. USA 2008, 105, 3963–3967. [Google Scholar] [CrossRef] [Green Version]
- Zuber, B.; Chami, M.; Houssin, C.; Dubochet, J.; Griffiths, G.; Daffé, M. Direct visualization of the outer membrane of mycobacteria and corynebacteria in their native state. J. Bacteriol. 2008, 190, 5672–5680. [Google Scholar] [CrossRef] [Green Version]
- Chiaradia, L.; Lefebvre, C.; Parra, J.; Marcoux, J.; Burlet-Schiltz, O.; Etienne, G.; Tropis, M.; Daffé, M. Dissecting the mycobacterial cell envelope and defining the composition of the native mycomembrane. Sci. Rep. 2017, 7, 12807. [Google Scholar] [CrossRef] [Green Version]
- Jackson, M. The mycobacterial cell envelope-lipids. Cold Spring Harb. Perspect. Med. 2014, 4, 1–22. [Google Scholar] [CrossRef] [Green Version]
- The Actinobacteriophage Database. Available online: https://phagesdb.org/ (accessed on 29 June 2021).
- Gil, F.; Catalão, M.J.; Moniz-Pereira, J.; Leandro, P.; McNeil, M.; Pimentel, M. The lytic cassette of mycobacteriophage Ms6 encodes an enzyme with lipolytic activity. Microbiology 2008, 154, 1364–1371. [Google Scholar] [CrossRef] [PubMed] [Green Version]
- Gil, F.; Grzegorzewicz, A.E.; Catalão, M.J.; Vital, J.; McNeil, M.R.; Pimentel, M. Mycobacteriophage Ms6 LysB specifically targets the outer membrane of Mycobacterium smegmatis. Microbiology 2010, 156, 1497–1504. [Google Scholar] [CrossRef] [Green Version]
- Payne, K.; Sun, Q.; Sacchettini, J.; Hatfull, G.F. Mycobacteriophage lysin B is a novel mycolylarabinogalactan esterase. Mol. Microbiol. 2009, 73, 367–381. [Google Scholar] [CrossRef] [Green Version]
- Gigante, A.; Hampton, C.; Dillard, R.; Gil, F.; Catalão, M.J.; Moniz-Pereira, J.; Wright, E.R.; Pimentel, M. The Ms6 mycolyl-arabinogalactan esterase lysB is essential for an efficient mycobacteriophage-induced lysis. Viruses 2017, 9, 343. [Google Scholar] [CrossRef] [PubMed] [Green Version]
- Henry, M.; Coffey, A.; O’Mahony, J.M.; Sleator, R.D. Comparative modelling of LysB from the mycobacterial bacteriophage Ardmore. Bioeng. Bugs 2011, 2, 88–95. [Google Scholar] [CrossRef] [PubMed]
- Van Kessel, J.C.; Hatfull, G.F. Recombineering in Mycobacterium tuberculosis. Nat. Methods 2007, 4, 147–152. [Google Scholar] [CrossRef]
- Nair, D.; Memmi, G.; Hernandez, D.; Bard, J.; Beaume, M.; Gill, S.; Francois, P.; Cheung, A.L. Whole-genome sequencing of Staphylococcus aureus strain RN4220, a key laboratory strain used in virulence research, identifies mutations that affect not only virulence factors but also the fitness of the strain. J. Bacteriol. 2011, 193, 2332–2335. [Google Scholar] [CrossRef] [PubMed] [Green Version]
- Zighelboim, S.; Tomasz, A. Penicillin-binding proteins of multiply antibiotic-resistant South African strains of penicillin-binding proteins of multiply antibiotic-resistant South African strains of Streptococcus pneumoniae. Antimicrob. Agents Chemother. 1980, 17, 434–442. [Google Scholar] [CrossRef] [Green Version]
- Snapper, S.B.; Melton, R.E.; Mustafa, S.; Kieser, T.; Jacobs, W.R., Jr. Isolation and characterization of efficient plasmid transformation mutants of Mycobacterium smegmatis. Mol. Microbiol. 1990, 4, 1911–1919. [Google Scholar] [CrossRef]
- Portugal, I.; Anes, E.; Moniz-Pereira, J. Temperate mycobacteriophage from M. smegmatis. Acta Leprol. 1989, 1, 234–244. [Google Scholar]
- Sambrook, J.; Russell, D.W. Molecular Cloning: A Laboratory Manual, 3rd ed.; Cold Spring Harbor Laboratory Press: Cold Spring Harbor, NY, USA, 2001. [Google Scholar]
- Abràmoff, M.D.; Magalhães, P.J.; Ram, S.J. Image processing with ImageJ. Biophotonics Int. 2004, 11, 36–42. [Google Scholar]
- Filipe, S.R.; Tomasz, A.; Ligoxygakis, P. Requirements of peptidoglycan structure that allow detection by the Drosophila Toll pathway. EMBO Rep. 2005, 6, 327–333. [Google Scholar] [CrossRef] [PubMed] [Green Version]
- Hayashi, K. A rapid determination of sodium dodecyl sulfate with methylene blue. Anal. Biochem. 1975, 67, 503–506. [Google Scholar] [CrossRef]
- Bhamidi, S.; Scherman, M.S.; Rithner, C.D.; Prenni, J.E.; Chatterjee, D.; Khoo, K.H.; McNeil, M.R. The identification and location of succinyl residues and the characterization of the interior arabinan region allow for a model of the complete primary structure of Mycobacterium tuberculosis mycolyl arabinogalactan. J. Biol. Chem. 2008, 283, 12992–13000. [Google Scholar] [CrossRef] [Green Version]
- Vaz, F.; Kounatidis, I.; Covas, G.; Parton, R.M.; Harkiolaki, M.; Davis, I.; Filipe, S.R.; Ligoxygakis, P. Accessibility to peptidoglycan is important for the recognition of gram-positive bacteria in Drosophila. Cell Rep. 2019, 27, 2480–2492. [Google Scholar] [CrossRef] [PubMed] [Green Version]
- Marinelli, L.J.; Piuri, M.; Swigoňová, Z.; Balachandran, A.; Oldfield, L.M.; van Kessel, J.C.; Hatfull, G.F. BRED: A simple and powerful tool for constructing mutant and recombinant bacteriophage genomes. PLoS ONE 2008, 3, e3957. [Google Scholar] [CrossRef] [Green Version]
- Catalão, M.J.; Gil, F.; Moniz-Pereira, J.; Pimentel, M. The mycobacteriophage Ms6 encodes a chaperone-like protein involved in the endolysin delivery to the peptidoglycan. Mol. Microbiol. 2010, 77, 672–686. [Google Scholar] [CrossRef]
- Söding, J.; Biegert, A.; Lupas, A.N. The HHpred interactive server for protein homology detection and structure prediction. Nucleic Acids Res. 2005, 33, 244–248. [Google Scholar] [CrossRef] [PubMed] [Green Version]
- Hildebrand, A.; Remmert, M.; Biegert, A.; Söding, J. Fast and accurate automatic structure prediction with HHpred. Proteins Struct. Funct. Bioinf. 2009, 77, 128–132. [Google Scholar] [CrossRef] [Green Version]
- MotifFinder. Available online: https://www.genome.jp/tools/motif/ (accessed on 24 May 2021).
- Payne, K.M.; Hatfull, G.F. Mycobacteriophage endolysins: Diverse and modular enzymes with multiple catalytic activities. PLoS ONE 2012, 7, e34052. [Google Scholar] [CrossRef] [PubMed] [Green Version]
- Briers, Y.; Volckaert, G.; Cornelissen, A.; Lagaert, S.; Michiels, C.W.; Hertveldt, K.; Lavigne, R. Muralytic activity and modular structure of the endolysins of Pseudomonas aeruginosa bacteriophages ΦKZ and EL. Mol. Microbiol. 2007, 65, 1334–1344. [Google Scholar] [CrossRef] [PubMed]
- Waterhouse, A.; Bertoni, M.; Bienert, S.; Studer, G.; Tauriello, G.; Gumienny, R.; Heer, F.T.; de Beer, T.A.P.; Rempfer, C.; Bordoli, L.; et al. SWISS-MODEL: Homology modelling of protein structures and complexes. Nucleic Acids Res. 2018, 46, W296–W303. [Google Scholar] [CrossRef] [PubMed] [Green Version]
- Studer, G.; Tauriello, G.; Bienert, S.; Biasini, M.; Johner, N.; Schwede, T. ProMod3—A versatile homology modelling toolbox. PLoS Comput. Biol. 2021, 17, 1–18. [Google Scholar] [CrossRef] [PubMed]
- Biasini, M.; Schmidt, T.; Bienert, S.; Mariani, V.; Studer, G.; Haas, J.; Johner, N.; Schenk, A.D.; Philippsen, A.; Schwede, T. Openstructure: An integrated software framework for computational structural biology. Acta Crystallogr. Sect. D Biol. Crystallogr. 2013, 69, 701–709. [Google Scholar] [CrossRef] [Green Version]
- Pettersen, E.F.; Goddard, T.D.; Huang, C.C.; Couch, G.S.; Greenblatt, D.M.; Meng, E.C.; Ferrin, T.E. UCSF Chimera—A visualization system for exploratory research and analysis. J. Comput. Chem. 2004, 25, 1605–1612. [Google Scholar] [CrossRef] [Green Version]
- Manganelli, R.; Dubnau, E.; Tyagi, S.; Kramer, F.R.; Smith, I. Differential expression of 10 sigma factor genes in Mycobacterium tuberculosis. Mol. Microbiol. 1999, 31, 715–724. [Google Scholar] [CrossRef] [PubMed]
- Yamamura, H.; Harayama, S. Method for selective isolation of mycobacteria using olive oil emulsified with SDS. Biosci. Biotechnol. Biochem. 2007, 71, 1553–1556. [Google Scholar] [CrossRef] [PubMed]
- Schleifer, K.H.; Kandler, O. Peptidoglycan types of bacterial cell walls and their taxonomic implications. Bacteriol. Rev. 1972, 36, 407–477. [Google Scholar] [CrossRef]
- Vollmer, W.; Blanot, D.; de Pedro, M.A. Peptidoglycan structure and architecture. FEMS Microbiol. Rev. 2008, 32, 149–167. [Google Scholar] [CrossRef] [Green Version]
- Garcia, M.; Pimentel, M.; Moniz-Pereira, J. Expression of mycobacteriophage Ms6 lysis genes is driven by two σ70-like promoters and is dependent on a transcription termination signal present in the leader RNA. J. Bacteriol. 2002, 184, 3034–3043. [Google Scholar] [CrossRef] [Green Version]
- Vollmer, W.; Joris, B.; Charlier, P.; Foster, S. Bacterial peptidoglycan (murein) hydrolases. FEMS Microbiol. Rev. 2008, 32, 259–286. [Google Scholar] [CrossRef] [PubMed] [Green Version]
- Vocadlo, D.J.; Davies, G.J.; Laine, R.; Withers, S.G. Catalysis by hen egg-white lysozyme proceeds via a covalent intermediate. Nature 2001, 412, 835–838. [Google Scholar] [CrossRef]
- Raymond, J.B.; Mahapatra, S.; Crick, D.C.; Pavelka, M.S. Identification of the namH gene, encoding the hydroxylase responsible for the N-glycolylation of the mycobacterial peptidoglycan. J. Biol. Chem. 2005, 280, 326–333. [Google Scholar] [CrossRef] [PubMed] [Green Version]
- Vollmer, W. Structural variation in the glycan strands of bacterial peptidoglycan. FEMS Microbiol. Rev. 2008, 32, 287–306. [Google Scholar] [CrossRef]
- Multiple Sequence Alignment by CLUSTALW. Available online: https://www.genome.jp/tools-bin/clustalw (accessed on 28 June 2021).

| Bacteria, Plasmids and Bacteriophages | Description | Source and Reference |
|---|---|---|
| Bacteria | ||
| E. coli JM109 | recA1 endA1 gyr96 thi hsdR17 supE44 relA1 Δ(lac-proAB) [F’ traD36 proAB lacIqZΔM15] | Stratagene |
| Bacillus subtillis MB24 | trpC2 metC3 | Laboratory stock |
| Staphylococcus aureus RN4220 | Restriction-deficient derivative of S. aureus NCTC8325-4 strain capable of receiving foreign DNA | [24] |
| Streptococcus pneumoniae Pen6 | R6Hex transformant with chromosomal DNA from penicillin resistant clinical isolate 8249 and selected for PenR | [25] |
| Pseudomonas aeruginosa | ATCC 27853 | American type culture collection |
| Mycobacterium smegmatis mc2155 | High-transformation-efficiency mutant of M. smegmatis ATCC 607 | [26] |
| M. smegmatis mc2155 (pJV53) | Recombinant strain containing plasmid pJV53 which expresses recombineering functions | [23] |
| Mycobacterium tuberculosis H37Ra | ATCC 25177 | American type culture collection |
| Mycobacterium vaccae | SN 901 (IPP) | Institut Pasteur Production |
| Mycobacterium bovis BCG (Pasteur) | ATCC 35734 | American type culture collection |
| Plasmids | ||
| pQE30 | Expression vector; T5 promoter; Ampr | Qiagen |
| pMP302 | Ms6 lysB cloned into pQE30 | [19] |
| pEGFP-N1 | Vector containing the EGFP coding sequence | Clontech Laboratories |
| pQE30:egfp | egfp fragment cloned into pQE30 | This study |
| pQE30:PGBD-egfp | Ms6 LysB PGBD coding sequence fused to egfp inserted into pQE30 | This study |
| Bacteriophages | ||
| Ms6 | Temperate bacteriophage from M. smegmatis. | [27] |
| Ms6lysB∆PGBD | Ms6 derivative mutant lacking the PGBD coding sequence | This study |
| Ms6∆lysB | 996 bp in-frame deletion of the Ms6 lysB gene | [21] |
Publisher’s Note: MDPI stays neutral with regard to jurisdictional claims in published maps and institutional affiliations. |
© 2021 by the authors. Licensee MDPI, Basel, Switzerland. This article is an open access article distributed under the terms and conditions of the Creative Commons Attribution (CC BY) license (https://creativecommons.org/licenses/by/4.0/).
Share and Cite
Gigante, A.M.; Olivença, F.; Catalão, M.J.; Leandro, P.; Moniz-Pereira, J.; Filipe, S.R.; Pimentel, M. The Mycobacteriophage Ms6 LysB N-Terminus Displays Peptidoglycan Binding Affinity. Viruses 2021, 13, 1377. https://doi.org/10.3390/v13071377
Gigante AM, Olivença F, Catalão MJ, Leandro P, Moniz-Pereira J, Filipe SR, Pimentel M. The Mycobacteriophage Ms6 LysB N-Terminus Displays Peptidoglycan Binding Affinity. Viruses. 2021; 13(7):1377. https://doi.org/10.3390/v13071377
Chicago/Turabian StyleGigante, Adriano M., Francisco Olivença, Maria João Catalão, Paula Leandro, José Moniz-Pereira, Sérgio R. Filipe, and Madalena Pimentel. 2021. "The Mycobacteriophage Ms6 LysB N-Terminus Displays Peptidoglycan Binding Affinity" Viruses 13, no. 7: 1377. https://doi.org/10.3390/v13071377
APA StyleGigante, A. M., Olivença, F., Catalão, M. J., Leandro, P., Moniz-Pereira, J., Filipe, S. R., & Pimentel, M. (2021). The Mycobacteriophage Ms6 LysB N-Terminus Displays Peptidoglycan Binding Affinity. Viruses, 13(7), 1377. https://doi.org/10.3390/v13071377

